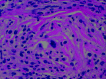

Extramedullary hematopoiesis involving the bilateral lacrimal fossae
- PMID: 16611795
- PMCID: PMC8133977
Extramedullary hematopoiesis involving the bilateral lacrimal fossae
Abstract
Extramedullary hematopoiesis is a complication of a number of myeloproliferative disorders. MR imaging of the orbits was performed in a patient with bilateral orbital swelling with known myeloproliferative disorder and myelofibrosis. The study revealed symmetric, bilateral enhancing masses in the lacrimal fossae extending into the nasolacrimal ducts. Biopsy demonstrated sclerotic extramedullary hematopoietic tumor.
Figures

References
-
- Choi H, David CL, Katz RL, et al. Case 69: extramedullary hematopoiesis. Radiology 2004;231:52–56 - PubMed
-
- Aronsohn MS, Antonelli PJ, Mancuso A. Extramedullary hematopoiesis presenting as a middle ear mass. Otol Neurotol 2003;24:963–64 - PubMed
-
- Aydingoz U, Oto A, Cila A. Spinal cord compression due to epidural extramedullary hematopoiesis in thalassaemia: MRI. Neuroradiology 1997;39:870–72 - PubMed
-
- Koch CA, Li CY, Mesa RA, et al. Nonhepatosplenic extramedullary hematopoiesis: associated diseases, pathology, clinical course, and treatment. Mayo Clin Proc 2003;78:1223–33 - PubMed
Publication types
MeSH terms
LinkOut - more resources
Full Text Sources